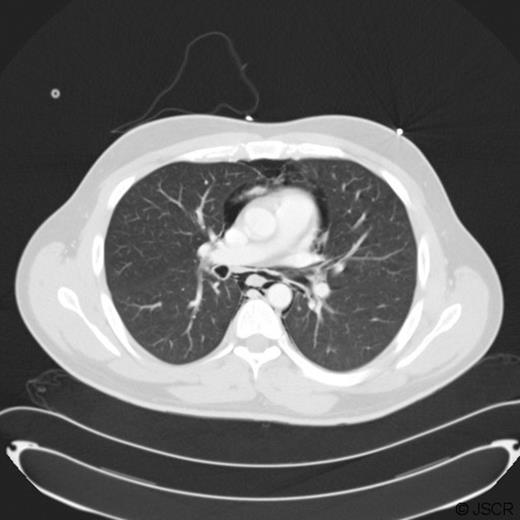
CT scan demonstrating pneumomediastinum.

-
PDF
- Split View
-
Views
-
Cite
Cite
Kunal Chudasama, Marlon Seenath, David Gourevitch, Pneumomediastinum after cocaine use: an unusual aetiology, Journal of Surgical Case Reports, Volume 2010, Issue 1, March 2010, Page 3, https://doi.org/10.1093/jscr/2010.1.3
Close - Share Icon Share
Abstract
We describe an interesting case of pneumomediastinum secondary to cocaine abuse. The patient presented with severe chest pain following nasal inhalation of a large quantity of cocaine. Investigations revealed no chest injury; however oesophagitis was proven leading to a possible aetiology of oesophageal microperforation. After conservative management there was spontaneous resolution of the pneumomediastinum.
INTRODUCTION
Pneumomediastinum is defined as air or free gas in the mediastinum, which invariably arises from the alveolar spaces or the conducting airways and has a multi-factorial aetiology. It is a benign and self-limiting condition that usually affects young males (1). Although uncommon, this condition is increasingly seen in Emergency Departments owing to the epidemic rise of substance abuse; an effect which is thought to be related to the mechanism of intoxication rather than pharmacology of the offending compound (2). We report here an interesting case of cocaine induced pneumomediastinum.
CASE REPORT
A fit and healthy 27 year old gentleman presented to the Accident and Emergency department complaining of severe sharp central chest pain and vertigo. There were no other symptoms of note and his past medical history and family history were unremarkable for respiratory or cardiovascular disease. On examination his vital signs were stable with oxygen saturation at 99% on air. The examinations of his respiratory and cardiovascular systems were unremarkable.
His blood tests showed a CRP 36, with all other hematological and biochemical parameters within normal levels. An electrocardiogram and serum troponin were unremarkable. A chest X-ray (Fig. 1) was performed to exclude pneumothorax but surprisingly revealed pneumomediastinum. He was admitted and transferred to the care of the surgical team with a diagnosis of suspected bronchial or oesophageal perforation. Computer Tomography (CT) Thorax imaging (Fig. 2) confirmed the presence of a pneumomediastinum extending from the lower neck at the level of C6 to the diaphragmatic hiatus. There were no visible mediastinal collections and no evidence of pulmonary /airway disease with intact pulmonary vessels. An oesophageal perforation was suspected but not shown on a water-soluble contrast swallow.

Reassessment of the patient's personal history revealed that he had nasally inhaled powdered cocaine prior to the onset of his symptoms. He denied the use of other recreational substances although he admitted to a significant history of smoking and alcohol use. The patient was managed conservatively during the course of his admission with simple analgesia and IV maintenance fluids. Repeat chest radiographs demonstrated resolution of his pneumomediastinum. His condition rapidly improved and he was discharged with plans for outpatient review.
Two weeks after discharge from hospital he was readmitted with similar symptoms. Chest radiography did not reveal any pneumomediastinum. A gastrograffin contrast swallow showed no evidence of an esophageal leak. An upper GI endoscopy revealed oesophagitis for which he was commenced on a proton pump inhibitor. Therefore with the low probability of lung injury, a possible diagnosis of micro-perforation of the oesophagus was made. Once again, the patient was managed conservatively and was discharged a few days later symptom free.
DISCUSSION
Pneumomediastinum results from air in the mediastinal fascial planes. Its occurrence secondary to cocaine inhalation has been reported in the literature as a known but uncommon event. The presumed patho-physiology of acute cocaine medicated lung injury is believed to arise from a sequence of events that begin with inhalation induced bronschospasm, increased alveolar pressure followed by alveolar rupture leading to interstitial emphysema and pneumomediastinum (3). Patients are generally young and present hours after cocaine inhalation with symptoms of acute onset chest pain, neck pain and surgical emphysema. Their vital signs will reveal a high respiratory rate and low oxygen saturation. In some institutions the term “crack lung” is more commonly used to identify this phenomenom (4).
Feliciano et al have reported cocaine induced gastro-intestinal perforations and these events are said to be due to co-existing H.pylori infection leading to mucosal weakness, which is then exacerbated by valsalva action (5). Our case report demonstrates evidence of inflammation of the oesophagus, and low probability of a lung injury in the setting of pneumomediastinum secondary to cocaine use. Indeed we postulate that oesophagitis may also contribute to mucosal weakness leading to microperforation of the oesophagus and thereafter pneumomediastinum.
The underlying aetiology of the pneumomediastinum in this case is unclear. However with no signs of lung injury on examination or investigations, microperforation in the setting of oesophagitis seems to be the most likely cause. The patient made an uneventful recovery with conservative management despite a dramatic clinical presentation. His continued use of cocaine despite counseling and community support is likely to place him at risk of recurrent episodes. Repeat microperforations on the background of oesophagitis may predispose this patient to an oesophageal catastrophe with mediastinal contamination and sepsis. The use of a proton pump inhibitor to promote oesophageal healing may be important in preventing such an outcome. Compliance, however, may be an issue.